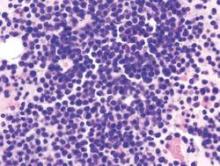

The first recipient of CTL019 for advanced refractory multiple myeloma achieved a durable complete response without developing cytokine release syndrome, according to a study published Sept. 9 in the New England Journal of Medicine.
“Twelve months after transplantation, the patient had no evidence of monoclonal immunoglobulin on serum and urine immunofixation and no clinical signs or symptoms of multiple myeloma,” said Dr. Alfred Garfall and his associates at the University of Pennsylvania in Philadelphia. “This response was achieved despite the absence of CD19 expression in 99.95% of the patient’s neoplastic plasma cells.”
CTL019 consists of autologous T cells modified to express an anti-CD19 chimeric antigen receptor (CAR) from a lentiviral vector. The cell therapy has yielded promising results in relapsed/refractory CLL and ALL,but was overlooked in MM because it was thought to infrequently express CD19, the researchers said.
“Several reports, however, have suggested that a minor component of the MM clone with drug-resistant, disease-propagating properties has a B-cell (i.e., CD19-positive) phenotype,” they noted. “In addition, our unpublished observations suggest that neoplastic plasma cells express low levels of CD19” (N Engl J Med. 2015 Sep 9;373:1040-7).
In response, they designed a pilot trial of adults whose MM relapsed or progressed within a year after initial autologous stem cell transplant. The first participant, a 43-year-old woman with IgA kappa MM, partially responded to lenalidomide, bortezomib, and dexamethasone but progressed when therapy was paused to collect stem cells for transplant. She then partially responded to cisplatin, doxorubicin, cyclophosphamide, and etoposide followed by high-dose melphalan and ASCT, but progressed again and continued to worsen despite a total of nine lines of therapy. A bone marrow sample revealed more than 95% plasma cells when the patient began the CTL019 trial, the researchers said.
For the study, the patient received a lower melphalan dose (140 mg/m2 of body surface area), followed by ASCT, CTL019 starting 2 weeks later, and maintenance lenalidomide. On day 100, her tumor burden had dropped by 5-log10, the researchers said. She also did not develop cytokine release syndrome, they added.
So far, 10 patients have been treated on study, of whom six remain progression free, according to the investigators. “The only additional CTL019-attributable toxic effects observed have been one instance of grade 1 cytokine release syndrome and one instance of grade 3 enterocolitis due to autologous graft-versus-host disease,” they reported.
Novartis supported the study and approved the manuscript. The work was also funded by the National Institutes of Health, the International Society for Advancement of Cytometry, the University of Pennsylvania Institute or Translational Medicine and Therapeutics, and a Conquer Cancer Foundation Young Investigator Award. The University of Pennsylvania has licensed technologies involved in this trial to Novartis. Several scientists involved in this trial hold patents for these technologies. As a result of the licensing relationship with Novartis, the University of Pennsylvania receives significant financial benefit, and these inventors have benefited financially or may benefit in the future.